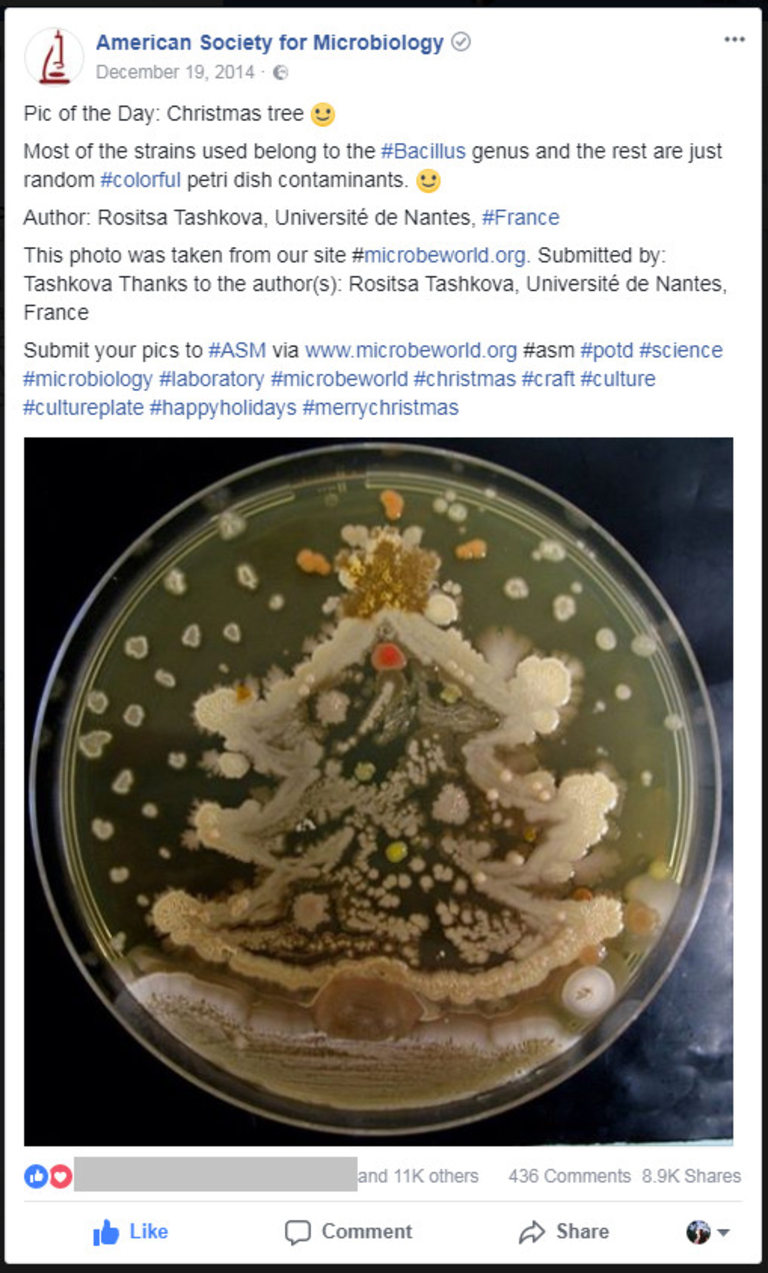

Когато мислим за изкуство, бактериите въобще не са първото нещо, което изплува в съзнанието ни. Микробиолози от България обаче показват неочакваната художествената страна на тези организми в изложбата "Агар Арт". Тя беше открита на 11 април и може да бъде разгледана до 11 май в Националния природонаучен музей. Изложбата включва 40 снимки на картини от микроорганизми.
В България началото на тази необичайна форма на изкуство бешее поставено през 2016 г. Тогава списание "Българска наука" и RIDACOM организираха първия в страната конкурс за рисунка с микроби по аналог на Agar Art Contest на Американското общество по микробиология.
Той пък е вдъхновен от създадената на шега бактериална елхичка, нарисувана върху агар от Росица Ташкова, която по онова време работи по дипломната си работа в Университета на Нант, Франция, а понастоящем е редактор на списание "Българска наука" (и наш автор, разбира се).
Източник: Facebook
Първото издание на конкурса предизвика много голям интерес и у нас. Той се проведе отново през 2017 г., като в него се включиха 25 участници, някои в екип, а други - сами. Микробиолози от цялата страна се впуснаха в предизвикателството да покажат своята креативност и художествени умения. И накрая представиха общо 140 произведения.

Източник: Росица Ташкова
Паун от бактерии
"Да рисуваш върху хранителна среда е вдъхновяващо, защото бактериите са активна част от творческия процес. Тези рисунки не само приличат на живи, те са живи и е нужно време да станат видими с просто око, да придобият форма и да разкрият цветовете си. А най-голямото удоволствие е да гледаш как създаденото от теб постоянно се променя", споделя Росица. "И тъй като микробиологичните бои са живи, произведението се развива за ден-два, демонстрира красотата си и след това започва отмира - истински микро кръговрат на живота."
"Агар Арт" е в в Националния природонаучен музей от 11 април до 11 май